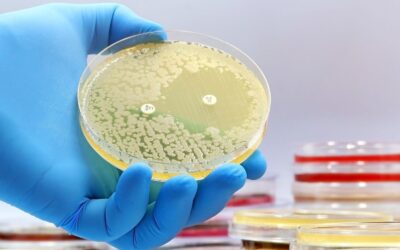
Understanding Antibiotic Resistance: How to Use Antibiotics Wisely

Understanding Antibiotic Resistance: How to Use Antibiotics Wisely
Antibiotic resistance has emerged as a significant public health challenge, threatening our ability to treat infectious diseases. Misuse and overuse of antibiotics contribute to this growing problem, leading to more dangerous bacterial strains. At Pioneer Pharmacy, we...
Join The 100 Club!
Managing your medications should never be a source of stress. At Pioneer Pharmacy in Riverton, Wyoming, we understand the importance of convenience and affordability when it comes to your health. With our 100 Club mail-order prescription services, you can get 100-day...
Pharmacogenomic or Genetic PGx Testing: Everything You Need to Know
Are you tired of medication trials? Imagine a healthcare approach where every pill prescribed is tailor-made for your body, ensuring not just efficacy but safety too. Here at Pioneer Pharmacy in Riverton, Wyoming, we are reshaping the way prescriptions are approached...
Allulose: The New Sugar-Replacing Sweetener
At Pioneer Pharmacy, we are always looking for innovative ways to improve the health and wellness of our community. Today, we are excited to dive into the topic of Allulose, a new sugar-replacing sweetener that is gaining popularity for its unique benefits. Visit our...
The Role of Vitamin Supplements in Supporting Immune Health
In today's fast-paced world, maintaining a strong and healthy immune system is more important than ever. At Pioneer Pharmacy, Riverton, Wyoming's trusted veteran-owned pharmacy, we understand the importance of taking proactive steps to boost our immunity. Let's delve...
Why Choose Pioneer Pharmacy
Elevate Your Healthcare Experience with Pioneer Pharmacy Pioneer Pharmacy is your trusted locally-owned pharmacy serving the Riverton, Wyoming community. At Pioneer Pharmacy, we pride ourselves on not just being a pharmacy, but a trusted healthcare partner dedicated...
How Pharmacogenomic Testing Can Reduce Adverse Drug Reactions
Through the advancements in pharmacogenomic (PGx) testing, the landscape of medication management is evolving, offering personalized solutions tailored to an individual's genetic makeup. At Pioneer Pharmacy in Wyoming, we are at the forefront of this innovative...
PGx Testing: The Future of Medicine Has Arrived
The 4th leading cause of death in the United States is adverse drug reactions (ADR). An adverse drug reaction is a harmful, unintended result caused by taking medication. Serious adverse drug events can result in hospitalization, permanent disability, and death. The...
Get Your Discounted Prescriptions in the Mail from a Wyoming-owned, Veteran-owned Pharmacy
Managing medications can sometimes feel daunting in today's fast-paced world. However, with the convenience of mail-order prescription services, staying on top of your health has never been easier. These services offer a simple solution for individuals to receive...
Here’s an informative video from the Mayo Clinic about PGx Testing. Take a look to learn more!
Here’s a video from the Mayo Clinic that features a testimonial from a patient. Watch it to learn more about the power of individualized medicine.